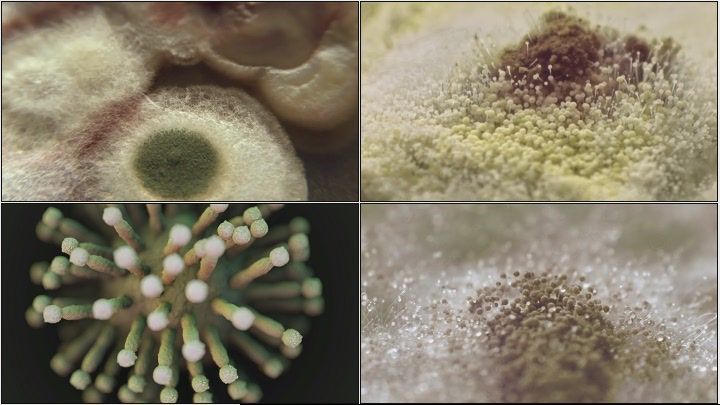
宝贝衣物衣服干净清洁细菌病毒

印度霉菌病毒图片

牛粪和牛尿不能治疗新冠,反而会增加"毛霉菌病"的感染,在印度新冠疫情
图片尺寸542x445
印度毛霉菌感染累计2万例已在多个国家出现难以买到救命药
图片尺寸1300x542
正在摧残许多印度新冠病毒患者,他们身上长出了许多"霉菌",导致眼睛等
图片尺寸918x506
印度发现的变异病毒现加强版广东新增确诊16天最低但深圳通报这一情况
图片尺寸1000x676
多种变异病株席卷印度,3万人中招,患者面部发霉痛不欲生|病毒|真菌
图片尺寸553x369
印度发现多种变异病菌,患者全身发霉还能传染
图片尺寸536x363
整个人发霉而亡印度成真菌培养皿致死率比新冠还高
图片尺寸960x540
印度,是实打实同时被病毒和真菌混合双打,左边是新冠,右边是黑毛霉菌
图片尺寸650x366
还可能滋生大量的细菌病毒,药性也发生了相对的变化,而且很多霉菌有很
图片尺寸640x401
谁来救救印度人战胜病毒却又感染真菌黑色霉菌在印炸锅
图片尺寸1000x717
印度成真菌"培养皿"?揭秘感染4大原因
图片尺寸519x297
整个人"发霉"而死,可怕疾病蔓延印度,与新冠病毒密切相关!
图片尺寸640x1138
161琼脂中模糊霉菌的宏观镜头1631霉菌病毒模式矢量无缝蓝色重复任何
图片尺寸324x216
印度疫情更恐怖了患者长出黑色霉菌甚至失去眼球案例在激增
图片尺寸1624x1080
宝贝衣物衣服干净清洁细菌病毒
图片尺寸720x405
基孔肯雅病毒vlp▲烟曲霉菌▲人类免疫缺陷病毒(hiv)埃博拉病毒颗粒
图片尺寸1280x720
印度又一致命疾病大爆发!
图片尺寸1080x608
被宠坏的腐烂卷心菜与霉菌霉菌病毒图标绿色矢量青黄色圆霉菌在黑色
图片尺寸300x300
原创死了51万人让德尔塔病毒传遍全球的印度突然间变得安全了
图片尺寸2000x1334
印度病毒已入侵我国,有三个想不到,三个难防护,我们该怎么办?
图片尺寸1200x800